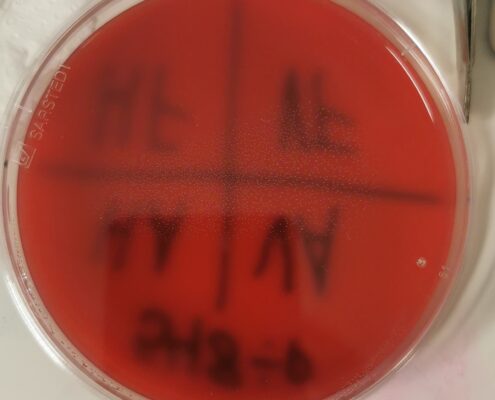

06.08.2023
Heute haben wir den Tag etwas später begonnen.
Unser Plan war es, einzukaufen für die letzte Woche und Souvenirs zu besorgen. Nach einem gemütlichen Frühstück sind wir dann zum Einkaufen in die Stadt gelaufen. Dabei ist uns aufgefallen, dass die Preise mindestens doppelt so hoch sind wie in Deutschland. Die einzige Ausnahme ist Lammfleisch. Das ist deutlich günstiger. Wegen der hohen Preise waren wir bis jetzt immer gezwungen darauf zu achten, wie viel und wofür wir Geld ausgeben.
Wieder zurück im Wohnheim haben alles verstaut und sind dann wieder in die Stadt für den Termin für Franziskas Tattoo. Wir wurden wieder herzlich von der Tätowiererin empfangen. Mit einem Kaffee und Gesprächen über Gott und die Welt bekam Franziska einen nordischen Kompass gestochen.
Überglücklich mit ihrem ersten richtigen Tattoo sind wir dann Souvenirs kaufen gegangen. Daheim haben wir uns dann erstmal Mittagessen gekocht und uns für 20:00 Uhr mit unseren neu gewonnen Freund:innen verabredet.
Ein paar Bier und nette Gespräche haben uns dann zum Highlight des Abends gebracht. Ein Feuerwerk zum Abschluss des Stadtfestes. 20 Minuten Lichter und Rauch. Auf den Kreuzfahrtschiffen wurden kleine Warnpistolen abgefeuert. Das war ein gelungener Abschluss für unsere zweite Woche!